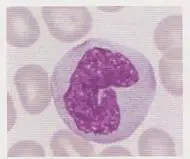
圖片描述

114年:(醫檢)血液(1)
圖①和圖②的圖示有核細胞各為何?

A①Neutrophil,②Eosinophil
B①Eosinophil,②Monocyte
C①Lymphocyte,②Neutrophil
D①Monocyte,②Basophil
詳細解析
本題觀念:
評估周邊血液塗片中常見白血球分類,重點在於辨識各種顆粒性及非顆粒性球的核型及胞質特徵。
影像分析:
圖①:可見一顆細胞,細胞大小較鄰近紅血球略大,核呈明顯不規則皺摺狀(horseshoe-或kidney-shaped),染色質分布鬆散(lace-like chromatin),胞質豐富且呈淡灰藍色,無明顯大型特異性顆粒,符合monocyte典型外觀 (bettybroadbent.com)。
圖②:細胞被大量深紫藍色粗大顆粒密集填滿,幾乎完全遮蔽核輪廓,顆粒大小不一但明顯大於中性或嗜酸性顆粒(granules obscure the nucleus),符合basophil特徵 (myhematology.com)。
選項分析
- 選項A (①Neutrophil,②Eosinophil)
①Neutrophil核分多葉(3–5 lobes)、胞質有淡粉紅色中性粒(neutroph
...(解析預覽)...

升級 VIP 解鎖圖文解析